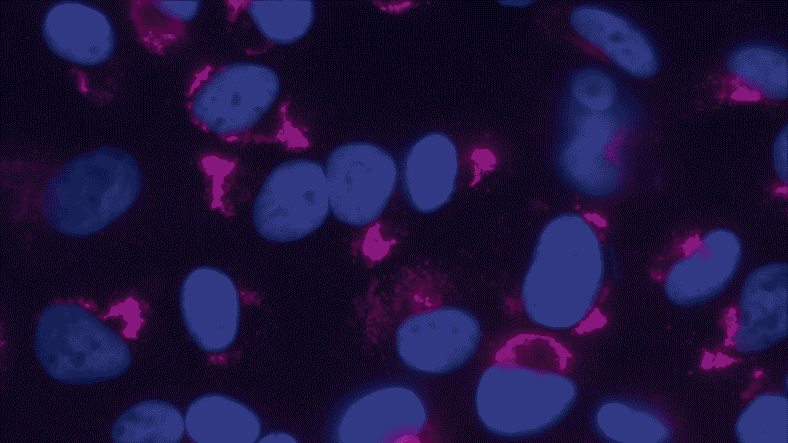

dsRNA J2 and K1 ELISA
Double-stranded RNA (dsRNA) can be a contaminant in mRNA vaccine preparations, potentially impacting their efficacy and safety. The KRIBIOLISA™ dsRNA ELISA Kit (J2 and K1 based) provides a reliable and efficient solution for detecting and quantifying dsRNA in your mRNA samples.
Why is dsRNA Detection Crucial for mRNA Vaccines?
- Purity Assurance: Ensure the purity of your mRNA preparations by identifying and removing dsRNA contaminants.
- Enhanced Efficacy: Minimize the potential negative effects of dsRNA on vaccine immunogenicity.
- Safety Compliance: Adhere to regulatory standards by demonstrating the absence of dsRNA in your vaccine products.


World’s first Pre-Coated DsRNA ELISA for J2 specific and K1 specific Detection
The J2 anti-dsRNA IgG2a monoclonal antibody (Schönborn et al. 1991) has become the gold standard in dsRNA detection. Krishgen’s robust and sensitive dsRNA ELISA kit allows qualitative / semi-quantitative screening of double stranded RNA in mRNA-based preparations. We recommend using the ELISA to detect viral dsRNAs or large natural or synthetic dsRNAs of non-viral origin in nucleic acid extracts, as well as to detect the presence of undesired dsRNA molecules in artificially synthesized (m)RNA preparations